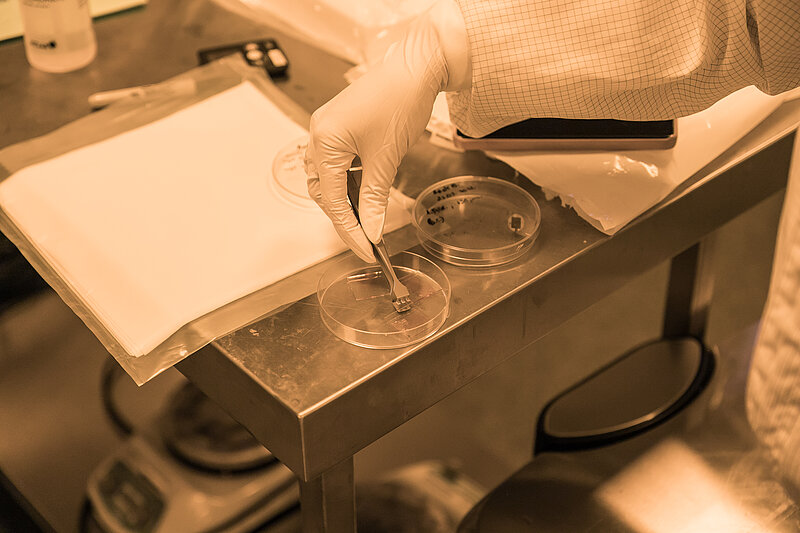

Studijas
Fizikas nodaļa nodrošina akadēmiskās fizikas studiju programmas bakalaura, maģistra un doktora līmenī.
Fizika

Bakalaura studiju programma
Fizika

Maģistra studiju programma
Fizika un astronomija

Dabaszinātņu doktora studiju programma
Pētniecība
Fizikas nodaļas sastāvā ietilpst sešas pētnieku grupas un studiju un pētniecības atbalsta vienības.
Vadītāja